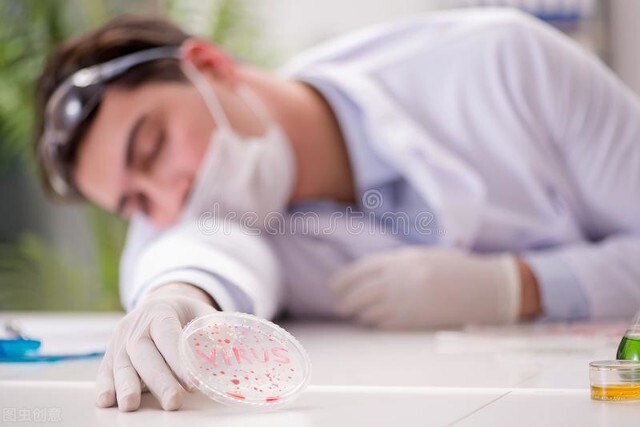
晚上失眠最有效的解决办法,失眠治疗仪治疗严重失眠管用吗

春节前, 发生了两件大学生猝死事件。
2021年11月27日。广东大学信息学院一名姓陈的男生被发现猝死在宿舍,据说经常在凌晨一到两点间睡觉。
2021年11月23日。34岁的辽宁工程技术学院的研三学生谢鹏倒在学校自习室。事发当天熬夜到凌晨二点半。
最近一项调查说:84%的90后存在睡眠困扰,有1/3是凌晨一点才入睡。根据睡眠数据报告显示:从2013年到2018年,中国人均睡眠时长已由8.8个小时,降至6.5个小时,平均38.2%的中国人有睡眠问题,比全球平均水平高出了11.2%。

前两天有友友问我:压力大,失眠严重怎么办?失眠已经成为神经科门诊的第二大疾病。我觉得这是很多人普遍存在的问题,所以就把自己知道的写出来,我们一起来讨论。
首先我们需要了解什么是失眠,你是不是真的失眠。一般情况下,我们在晚饭后三四个小时上床睡觉,天亮起床。有时会出现三种失眠情况。第一种躺在床上睡觉却怎么也睡不着,时间超过三十分钟。第二情况,夜里容易醒,超过两次。第三种早醒后睡不着,或者早醒后,超过三十分钟后才再次入睡。

不知友友是不是存在上面三种情况。如果存在的话,我们还要看第二天的精神状况,我们是不是感到很疲劳,情绪不稳定,烦燥易怒。失眠对我们第二天的工作、学习和生活有没有负向的影响。如果没有不好的影响,友友可以放心,所谓的失眠是我们内心的需要。比如我们为了完成一项任务熬夜到深夜或早早的起床。今年除夕夜,我就守岁到2点多,天亮后起床,正常的回老家拜年。

晚上没睡好,第二天起床后,头晕脑胀,记忆力不好,学习工作效率低,生活质量下降。我们可以午饭进行午休,睡一会儿,有可能会缓过来。如果我们的补救措施没有起到作用。这种情况一周内存在三天以上,一个月出现两周以上,我们就要用心对待。考虑到这是短性失眠障碍,短性失眠障碍通常和生活事件有关系。如果时间持续了至少三个月,我们要向慢性失眠障碍方面去想。

想改善睡眠,我们要了解失眠的诱发因素。失眠和年龄、心理、生理、环境、药物、生活行为、个性、精神及全身疾病等有关。一般来说。年纪大的人比年纪小的人容易失眠。生活中,有升学、就业、恋爱、分手、结婚、生孩子、家里人去世等重大事件出现容易失眠。女性来经期和更年期易失眠。睡眠的环境嘈杂容易失眠。睡觉前吸烟,喝酒,喝咖啡容易失眠。一些精神障碍患者得了抑郁症、焦虑症、双向情感障碍等疾病后容易失眠。身体上有身体疾病的也容易失眠。我们一般人夜晚睡觉,白天醒来,形成睡眠-觉醒的节奏。而以上各种因素,造成失眠者躯体、大脑皮层和认知三个方面的24小时的过度觉醒,造成失眠。

友友说自己失眠严重,你可以看看自己严重到程度。有三个方法可供叁考。
第一种 吃药 。找精神科医生治疗,他们经过检查诊断出失眠的真正原因,对症下药。我有个朋友,她最爱的父亲去世后,哭了整整一个月,夜里出现睡不着的现象,她和她的家人都是悲伤过度,属于正常,这样持续了一年多。后来去精神病医院看病,医生诊断为轻度抑郁症。失眠只是抑郁症的一种表现形式。失眠也容易发展为抑郁症。朋友从确诊到现在已有五年时间,她担心病情复发,每天坚持吃半片药。

第二种是加强 运动 。不知你有没有这样的经历,一天中不停的奔波,劳动,身体累得不行,晚上躺在床上就睡。我经历过这样的事。小时候,在农村,麦忙时节,从早到晚在田地里割麦子,装麦子,打场,累得晚饭都不想吃,只想睡觉。

第三种是 心理治疗 。有一种叫CBT的认知行为疗法。它有三个步骤:
1.刺激控制。睡前不吸烟,喝酒,喝咖啡,不做让大脑兴奋的事情。不困就不要躺在床上,困了再去睡,让睡眠和床重新建立关系。
2.放松训练。我常用的方法是腹式呼吸法。为了方便掌握腹式呼吸法。可以先将手放在腹部。当慢慢吸气的时候,心中默念“好好睡觉”四个字,腹部微微鼓起。缓缓的呼气时腹部瘪下,心中默念,“放松平静”4个字。通过几轮这样的腹式深呼吸之后,身体便完全放松,很快就会进入睡眠状态。如果不行的话,可以放一些自己喜欢的催眠音乐。我常放的音乐是冥想星球里面的冥想音乐。很多情况下是冥想音乐没有结束,我就进入了睡眠之中。
3.认知重构。对于失眠,我们要有一个正确的态度,不是所有的失眠都会有负向的影响。接纳有失眠有时候比对抗失眠效果更好。 记得一个友友在头条上说:凌晨3点睡不着,我给他的回答是看头条。在睡不着的这段时间里面,我们干自己想干的一些事情,也许有意外的收获。

我是笑葡萄,市妇联公益心理咨询师,你身边的普通人。请关注我,我们一起探索,思考,成长。